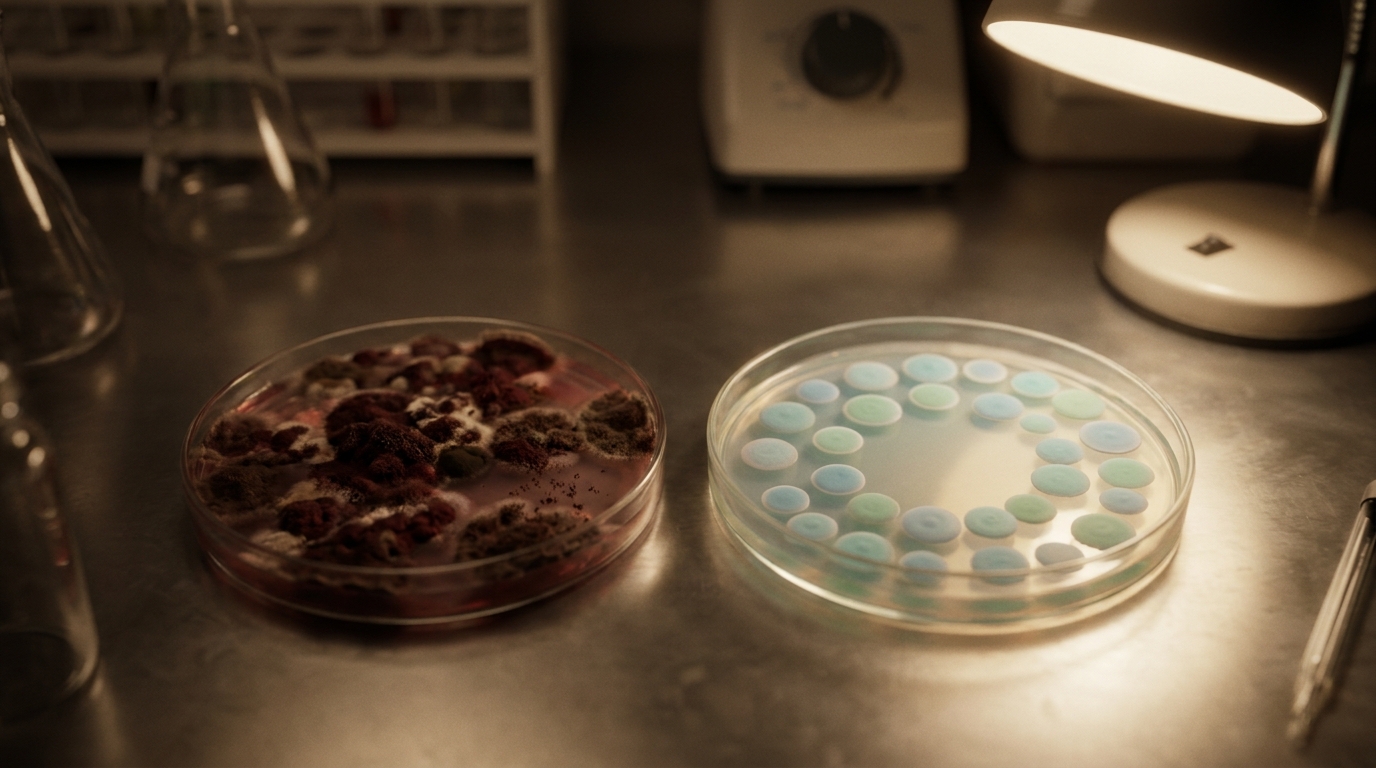
שתי צלחות פטרי המדגימות את ההבדל בין אוכלוסיית חיידקים לא מאוזנת הגורמת לאקנה לבין אוכלוסייה מאוזנת.

טיפול טבעי באקנה: האם חיידקים טובים הם הפתרון לפצעים?
אקנה, או בשמה העממי "פצעי בגרות", היא אחת מבעיות העור הנפוצות והמתסכלות ביותר, המשפיעה על נערים ונערות אך גם על מבוגרים רבים. המדפים בבתי המרקחת עמוסים בתכשירים המבטיחים עור חלק ונטול פגמים, אך רבים מהם מבוססים על גישה אגרסיבית: ייבוש, קילוף והשמדת חיידקים. התוצאה, במקרים רבים, היא עור מגורה, אדמומי, יבש ורגיש, ובטווח הארוך – חזרה של הפצעונים, לפעמים בעוצמה רבה יותר. התסכול הזה מוביל רבים לשאול: האם אנחנו נלחמים באויב הלא נכון? האם ייתכן שהפתרון לאקנה אינו במלחמה חסרת פשרות, אלא דווקא בהשבת האיזון העדין של העור? התשובה, באופן מפתיע, עשויה להימצא בעולם המיקרוסקופי של החיידקים הטובים.
אקנה: למה הטיפולים המוכרים לא תמיד עובדים?
הגישה הקונבנציונלית לטיפול באקנה מתמקדת לרוב בשלושה יעדים: הפחתת ייצור השומן (סבום), חיסול החיידק Cutibacterium acnes (לשעבר P. acnes), והפחתת הדלקת. הטיפולים הנפוצים כוללים תכשירים המכילים חומצה סליצילית, בנזואיל פראוקסיד, רטינואידים, ובמקרים חמורים יותר – אנטיביוטיקה (מקומית או דרך הפה) ואיזוטרטינואין (רואקוטן).
בעוד שטיפולים אלו יכולים להציע הקלה זמנית, הם מגיעים עם חסרונות משמעותיים. תכשירים רבים מייבשים את העור באופן קיצוני, פוגעים בשכבת ההגנה הטבעית שלו (מחסום העור) וגורמים לגירוי ואדמומיות. במצב כזה, העור עלול להגיב בייצור מוגבר של שומן כדי לפצות על היובש, מה שמחריף את הבעיה. השימוש באנטיביוטיקה, למרות יעילותו הראשונית, עלול להוביל להתפתחות עמידות של החיידקים, וחשוב מכך – הוא פוגע ללא הבחנה גם באוכלוסיית החיידקים המועילים, אלו ששומרים על בריאות העור שלנו.
התסכול מהמעגל החוזר של שיפור זמני והתפרצות מחודשת, יחד עם תופעות הלוואי, גורם לרבים לחפש גישה אחרת. גישה שמבינה כי עור בריא אינו עור סטרילי, אלא מערכת אקולוגית חיה ודינמית. כאן נכנס לתמונה המדע החדשני של המיקרוביום.
הכירו את הגיבורים השקטים שלכם: המיקרוביום של העור
על פני העור שלנו, בדומה למערכת העיכול, מתקיימת קהילה שלמה ותוססת של מיליארדי מיקרואורגניזמים – חיידקים, פטריות ווירוסים. המערכת האקולוגית המורכבת הזו נקראת המיקרוביום של העור. אפשר לדמיין אותה כגן בוטני עשיר, שבו לצד "עשבים שוטים" (חיידקים מזיקים) צומחים גם "צמחים מועילים" (חיידקים טובים) השומרים על בריאות הגן כולו. כל עוד נשמר האיזון בין האוכלוסיות השונות, העור שלנו נראה ומרגיש במיטבו.
לחיידקים ה"טובים", או החיידקים הפרוביוטיים, יש תפקידים חיוניים בשמירה על עור בריא:
- הגנה מפני פתוגנים: הם מהווים קו הגנה ראשון ומונעים מחיידקים מזיקים להתרבות ולגרום לזיהומים.
- שמירה על רמת חומציות (pH): הם מסייעים לשמור על ה-pH הטבעי והמעט חומצי של העור, סביבה שאינה אידיאלית לשגשוג חיידקים גורמי מחלות.
- וויסות המערכת החיסונית: הם "מתקשרים" עם תאי מערכת החיסון בעור ומסייעים למנוע תגובות דלקתיות מוגזמות.
- חיזוק מחסום העור: הם תורמים לייצור חומרים חיוניים שמחזקים את שכבת ההגנה של העור ומונעים אובדן לחות ורגישות.
כאשר האיזון העדין הזה מופר – עקב שימוש בתכשירים אגרסיביים, תזונה לקויה, סטרס או שינויים הורמונליים – החיידקים המזיקים, כמו C. acnes, מקבלים הזדמנות לשגשג. התרבות היתר שלהם, יחד עם ייצור מוגבר של סבום וסתימה של זקיקי השערה, מובילים לתגובה דלקתית – וזוהי למעשה ההתפרצות של אקנה. מכאן עולה ההבנה שהמטרה אינה לחסל את כל החיידקים, אלא לתמוך בחיידקים הטובים כדי שיחזירו את האיזון על כנו.
הקרב על העור: כך חיידקים טובים נלחמים בפצעונים
השימוש בפרוביוטיקה, כלומר, הוספה ממוקדת של חיידקים טובים, מהווה גישה מהפכנית לטיפול באקנה. במקום להילחם בעור, אנחנו מספקים לו את הכלים להילחם בעצמו ולהגן על עצמו. מחקרים קליניים עדכניים מראים כיצד חיידקים פרוביוטיים מסייעים להקל על תסמיני אקנה דרך מספר מנגנונים ביולוגיים מרתקים:
- תחרות על משאבים ומקום: בדומה לטבע, גם על העור שלנו מתקיימת תחרות מתמדת. כאשר אנחנו מעשירים את העור בחיידקים פרוביוטיים, הם פשוטו כמשמעו "תופסים את המקום" על פני העור. הם מתחרים עם חיידקי האקנה על מקורות מזון וחומרי הזנה חיוניים, ובכך מגבילים באופן טבעי את יכולתם להתרבות ולשגשג. זהו מנגנון אלגנטי שמצמצם את אוכלוסיית החיידקים המזיקים מבלי להשתמש בחומרים כימיים אגרסיביים.
- ייצור חומרים אנטי-בקטריאליים טבעיים: חיידקים פרוביוטיים מסוימים, כמו זנים ממשפחת הלקטובצילוס, הם "מפעלים זעירים" המייצרים חומרים הנקראים בקטריוצינים (Bacteriocins). אלו הן תרכובות טבעיות בעלות פעילות אנטי-מיקרוביאלית ממוקדת, הפוגעות באופן ספציפי במבנה התא של חיידקים מזיקים כמו C. acnes, תוך שהן מותירות את המיקרוביום המועיל ללא פגע.
- הפחתת דלקת ותגובת יתר חיסונית: אקנה היא בבסיסה מחלה דלקתית. הפצעונים האדומים והכואבים הם תוצאה של תגובת יתר של מערכת החיסון לנוכחות החיידקים והסבום. לחיידקים הפרוביוטיים יש יכולת מוכחת לווסת את התגובה החיסונית הזו. הם מסייעים "להרגיע" את התאים הדלקתיים בעור, מה שמוביל להפחתה משמעותית באדמומיות, בנפיחות וברגישות הנלווים לפצעים.
- חיזוק ותיקון מחסום העור: מחסום עור פגום הוא שער פתוח לזיהומים, גירויים ואובדן לחות. פרוביוטיקה מסייעת לשקם את המחסום הזה על ידי עידוד ייצור סרמידים וליפידים חיוניים. עור עם מחסום חזק ובריא הוא עמיד יותר, מאוזן יותר, ומסוגל להתמודד טוב יותר עם גורמים חיצוניים העלולים לעורר התפרצות אקנה.
לא כל פרוביוטיקה נולדה שווה: הכירו את טכנולוגיית YUN המהפכנית
כיום, המונח "פרוביוטיקה" הפך פופולרי בתעשיית הקוסמטיקה, אך חשוב להבין שיש הבדל עצום בין המוצרים השונים. רוב התכשירים בשוק מכילים תמציות, ליזאטים (שברי חיידקים) או חיידקים מתים. רכיבים אלה יכולים להציע תועלת מסוימת (למשל, בהרגעת העור), אך הם חסרים את היכולת המרכזית של פרוביוטיקה אמיתית: פעילות חיה ואינטראקציה דינמית עם המיקרוביום הקיים.
כאן נכנסת לתמונה הטכנולוגיה פורצת הדרך של YUN, שפותחה בבלגיה ומשולבת במוצרי טראסטפארם בע"מ. הייחוד של טכנולוגיה זו הוא פשוט אך מהפכני: המוצרים מכילים מיליוני חיידקים פרוביוטיים חיים ופעילים מזנים ספציפיים של לקטובצילוס, שנבחרו בזכות יעילותם המוכחת במלחמה בחיידקים הגורמים לאקנה וזיהומים אחרים.
אז איך זה עובד? האתגר הגדול ביותר היה לשמור על החיידקים בחיים בתוך תכשיר קוסמטי. הפתרון נמצא בפטנט ייחודי של מיקרו-קפסולציה. כל חיידק פרוביוטי חי נעטף בקפסולה זעירה המגנה עליו ושומרת עליו במצב רדום ויציב בתוך הקרם. רק כאשר מורחים את הקרם על העור, המגע עם הלחות והחום הטבעיים של העור ממיס את הקפסולות, משחרר את החיידקים, ו"מעיר" אותם לפעולה. ברגע שהם חופשיים, הם מתחילים מיד ליישב את העור, להתחרות בחיידקים המזיקים, להפחית דלקת ולשקם את האיזון האקולוגי. שיטה זו מבטיחה יעילות מקסימלית ויישום של פרוביוטיקה חיה בדיוק היכן שהיא נדרשת. לדוגמה, קרם ACN הפרוביוטי מיישם טכנולוגיה זו כדי לסייע באופן ממוקד בטיפול בעור הנוטה לאקנה.

שאלות נפוצות על טיפול פרוביוטי באקנה
למי מתאים טיפול פרוביוטי באקנה?
טיפול פרוביוטי מתאים למגוון רחב של אנשים, והוא יעיל במיוחד עבור אלו שחווים תסכול מטיפולים אחרים. הוא מהווה פתרון מצוין לסובלים מאקנה על רקע הורמונלי (הנפוץ בגיל ההתבגרות ובקרב נשים בוגרות), לבעלי עור רגיש שאינם יכולים לסבול תכשירים כימיים חזקים, וכן לאנשים שמחפשים גישה הוליסטית ובריאה יותר לטיפוח העור. במקום לפגוע בעור, הטיפול הפרוביוטי תומך במנגנוני ההגנה הטבעיים שלו, ולכן הוא מתאים לשימוש ארוך טווח כחלק משגרת טיפוח מאזנת.
האם זה בטוח להשתמש בחיידקים חיים על הפנים?
בהחלט. חשוב להדגיש כי מדובר בזנים ספציפיים של חיידקים פרוביוטיים (כמו לקטובצילוס), אשר נחקרו קלינית ונמצאו לא רק בטוחים לשימוש על העור אלא גם מועילים לו. אלו הם חיידקים שבאופן טבעי מהווים חלק מהמיקרוביום הבריא של העור. המטרה אינה להוסיף חייזרים זרים, אלא לחזק את אוכלוסיית ה"חיילים הטובים" שכבר קיימת, כדי שיחזירו את האיזון הטבעי על כנו. המוצרים עוברים בדיקות איכות ובטיחות מחמירות כדי להבטיח שהם עומדים בסטנדרטים הגבוהים ביותר של "Pharma Quality".
תוך כמה זמן אפשר לראות תוצאות?
בניגוד לטיפולים "אגרסיביים" שמייבשים פצעונים בן לילה (ולעיתים קרובות גורמים נזק נלווה), טיפול פרוביוטי הוא תהליך של שיקום. נדרש זמן כדי לשנות את המאזן האקולוגי על פני העור. משתמשים רבים מדווחים על תחושת רוגע בעור והפחתה באדמומיות כבר לאחר מספר שבועות של שימוש עקבי. שיפור משמעותי יותר במראה הפצעונים ובמרקם העור הכללי נראה בדרך כלל לאחר 4-8 שבועות. המפתח הוא התמדה, שכן אנחנו מאפשרים לעור "ללמוד" מחדש כיצד לאזן את עצמו.
הצעד הבא לעור בריא ומאוזן
הבנת המיקרוביום של העור משנה את כל מה שחשבנו על טיפול באקנה. המפתח לעור נקי ובריא אינו מלחמה כוללת וחורמה, אלא שיתוף פעולה חכם עם המערכת האקולוגית המופלאה שכבר קיימת על פני העור שלנו. במקום להרוס, לייבש ולקלף, הגישה החדשה דוגלת בבנייה, חיזוק ואיזון. אנו בטראסטפארם בע"מ, הדור הבא של חברות התרופות, מאמינים במדע פורץ דרך המגויס לטובת בריאות טבעית ועדינה.
הדרך לעור מאוזן מתחילה בשינוי תפיסתי ובבחירת מוצרים שתומכים בבריאות העור מהשורש. אם אתם מחפשים פתרון שלם המבוסס על טכנולוגיה זו, אנו ממליצים על ערכת הטיפול המלאה לאקנה. היא כוללת תרחיץ פנים עדין, פילינג מחדש וקרם ACN המכיל חיידקים פרוביוטיים חיים, ומציעה מענה הוליסטי לניקוי, חידוש ואיזון המיקרוביום של העור. זהו הצעד הראשון שלכם לעבר עור רגוע, בריא וחיוני יותר.
רוצים ללמוד עוד על בריאות העור ופתרונות חדשניים? בקרו בהבלוג שלנו למאמרים נוספים.





